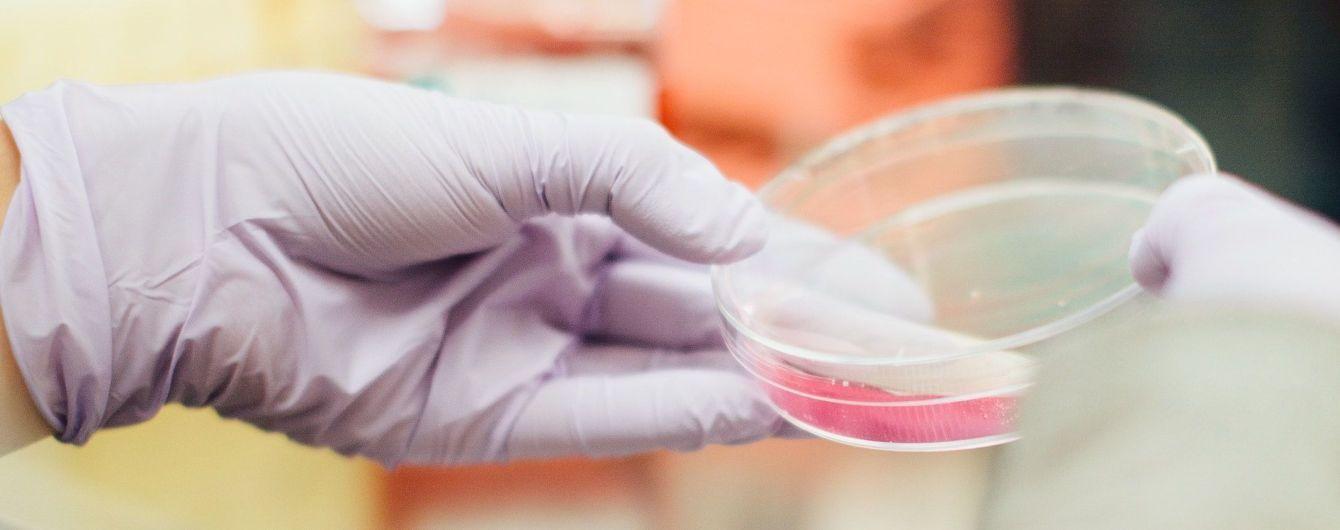

На Вінниччині кількість госпіталізованих через спалах гепатиту А зросла до 151
Фото: Unsplash/Drew Hays У Вінницькій області зросла кількість хворих на гепатит А – госпіталізували вже 151 людину.
Про це повідомило Міністерство охорони здоров’я України.
«Кількість хворих на гепатит А на Вінниччині зростає. У лікарні перебуває 151 пацієнт. Ще 25 – одужали, та наразі виписані із медзакладів», – ідеться у повідомленні.
Останні два дні команда МОЗ на чолі з головним державним санітарним лікарем Ігорем Кузіним працює на Вінниччині. На підставі проведених епідрозслідувань, встановлено щонайменше чотири можливих фактори, які вказують на джерело інфекції.
Кожен з факторів опрацьовується одночасно паралельними командами з широким лабораторним контролем. Наразі обстежено більш як 100 людей, робота яких пов’язана зі сферою послуг, водопостачанням та продуктами харчування, які могли стати джерелом інфекції.
Додатково, лікарі опитують хворих з підтвердженими діагнозами та уточнюють зв’язки, які вказують на спільне джерело інфікування.
«Сьогодні у Вінниці розпочали щеплення медиків. До області доставлено 1 060 доз вакцин, якими мають щепити медиків, лікарів «екстренки» та фахівців громадського здоров’я задіяних у ліквідації спалаху вірусного гепатиту А», – зазначили в МОЗ.
Нагадаємо, 24 жовтня у Вінниці зафіксували спалах вірусного гепатиту А в одному із районів міста. 25 жовтня міська комісія з питань техногенно-екологічної безпеки та надзвичайних ситуацій визнала спалах захворювання на вірусний гепатит А надзвичайною ситуацією.